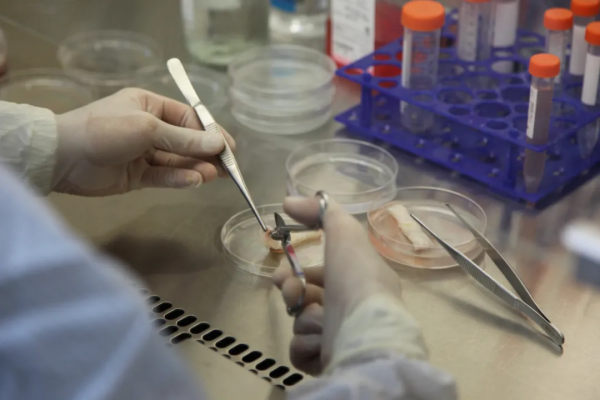
細胞到底能存多久？今天就來講講細胞凍存那些事兒

我們的身體是一個巨大的精密儀器,每一個器官都是其中重要的組成零件,細胞就是其中最基本也是最重要的元件。
如同機器需要定期維修、更換,人體也有自我修復機制,然而此現象是會隨著年齡的增長而不斷在身體裡累積,細胞的自我再生能力也會隨著年齡的增加而衰退。
如今很多人都為自己的健康做好了長遠規劃,選擇新型的個人健康管理方式——凍存免疫細胞。但是也有很多疑問:細胞凍存可以凍存多長時間?細胞復甦後活性如何?什麼時候凍存細胞的質量最高?
今天就來帶大家細數細胞凍存發展簡史,帶大家一起來了解一下細胞凍存的那些事兒。
細胞凍存技術初見雛形
1776年,Spallanzani最早發表了“冷”處理對“細胞”生命活動影響的報道。
十九世紀中後葉,許多早期的工作者重複研究了低溫處理對精子活動的影響,得出了和 Spallanzani相似的結論,即“冷不能殺死精子”。
1900年前後,科學家基本上肯定了生物成份能夠在零下溫度儲存的事實。
20世紀50年代,Luyet等多位學者發現了電解質濃度對儲存細胞的損傷作用,他們的基本結論是,電解質濃度增大是造成儲存細胞損傷的主要原因。
細胞凍存技術不斷髮展
60年代,美國紐約血液中心Rowe實現了紅細胞的低溫儲存。1980年,他將在液氮溫度下儲存了12年的紅細胞復甦後進行檢查,沒有發現任何生化和功能上的變異,從而從實踐上證明了生物材料可以在低溫下長期存活。
70年代,Mazur等首先根據中國倉鼠組織培養細胞的低溫儲存實驗資料分析,提出關於冷凍損傷的兩因素,即冰晶損傷和溶液損傷。
80年代以來,理學和工程學進入低溫儲存研究領域,低溫工程理論及實用設計原理的不斷更新及應用,低溫生物學的研究快速發展。
20世紀以來,人類的科學研究進入細胞水平階段,開始對生物和作為食品原料的生物材料進行低溫儲存處理。到了20世紀末,隨著科學方法的不斷進步以及冷凍方法的不斷完善,低溫儲存技術廣泛地應用到了臨床上。
細胞儲存知多少
1、細胞凍存可以凍存多長時間?
理論上可永久儲存。研究表明,細胞冷凍儲存在-70℃冰箱中可以儲存一年之久;細胞儲存在液氮中,溫度達-196℃,只要儲存得當,理論上儲存時間是無限的。
2、什麼時候凍存細胞的質量最高?
人體免疫力在20歲左右達到高峰,隨著年齡的增長,免疫細胞的活性越來越低,隨之而來的就是疾病發生率逐年上升。
因此,預先將健康的免疫細胞儲存在-196℃的深低溫液氮罐中,待到需要之時,即用即取,方便安心。今天的細胞永遠比明天的年輕,最好的儲存時間就在當下!
儲存細胞 儲存健康
隨著現代醫學的發展,科學家們對細胞前沿技術不斷探索與研究,細胞科技已經成為人類生命健康的有力保障,並在健康管理與疾病治療領域發揮了重要作用。
將健康充滿活力的免疫細胞儲存起來,成為越來越多的人為未來人生保駕護航的重要手段,儲存免疫細胞就是為自己投資一份健康財富!快來國衛生物儲存你的免疫細胞吧!